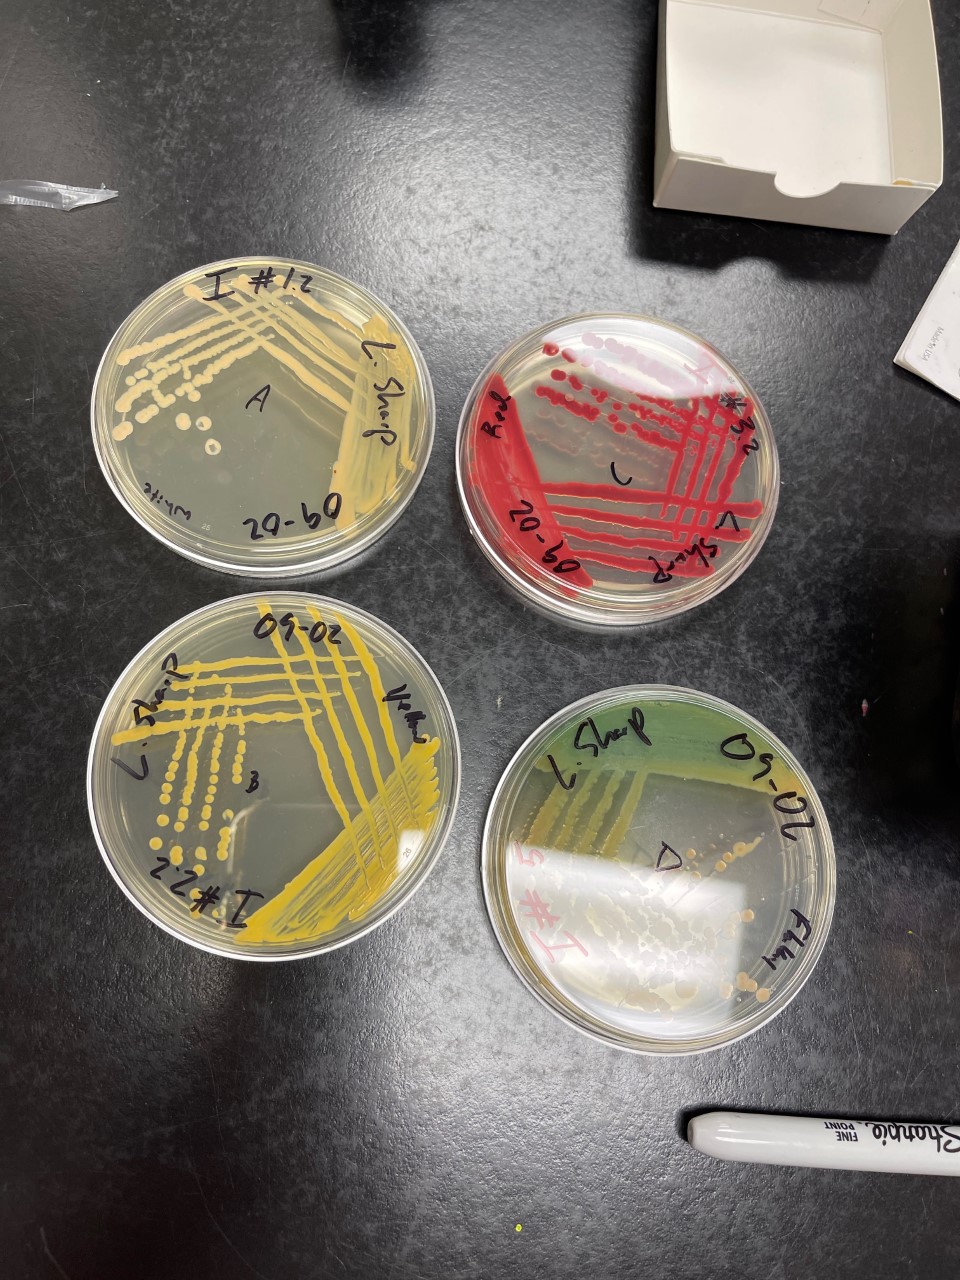
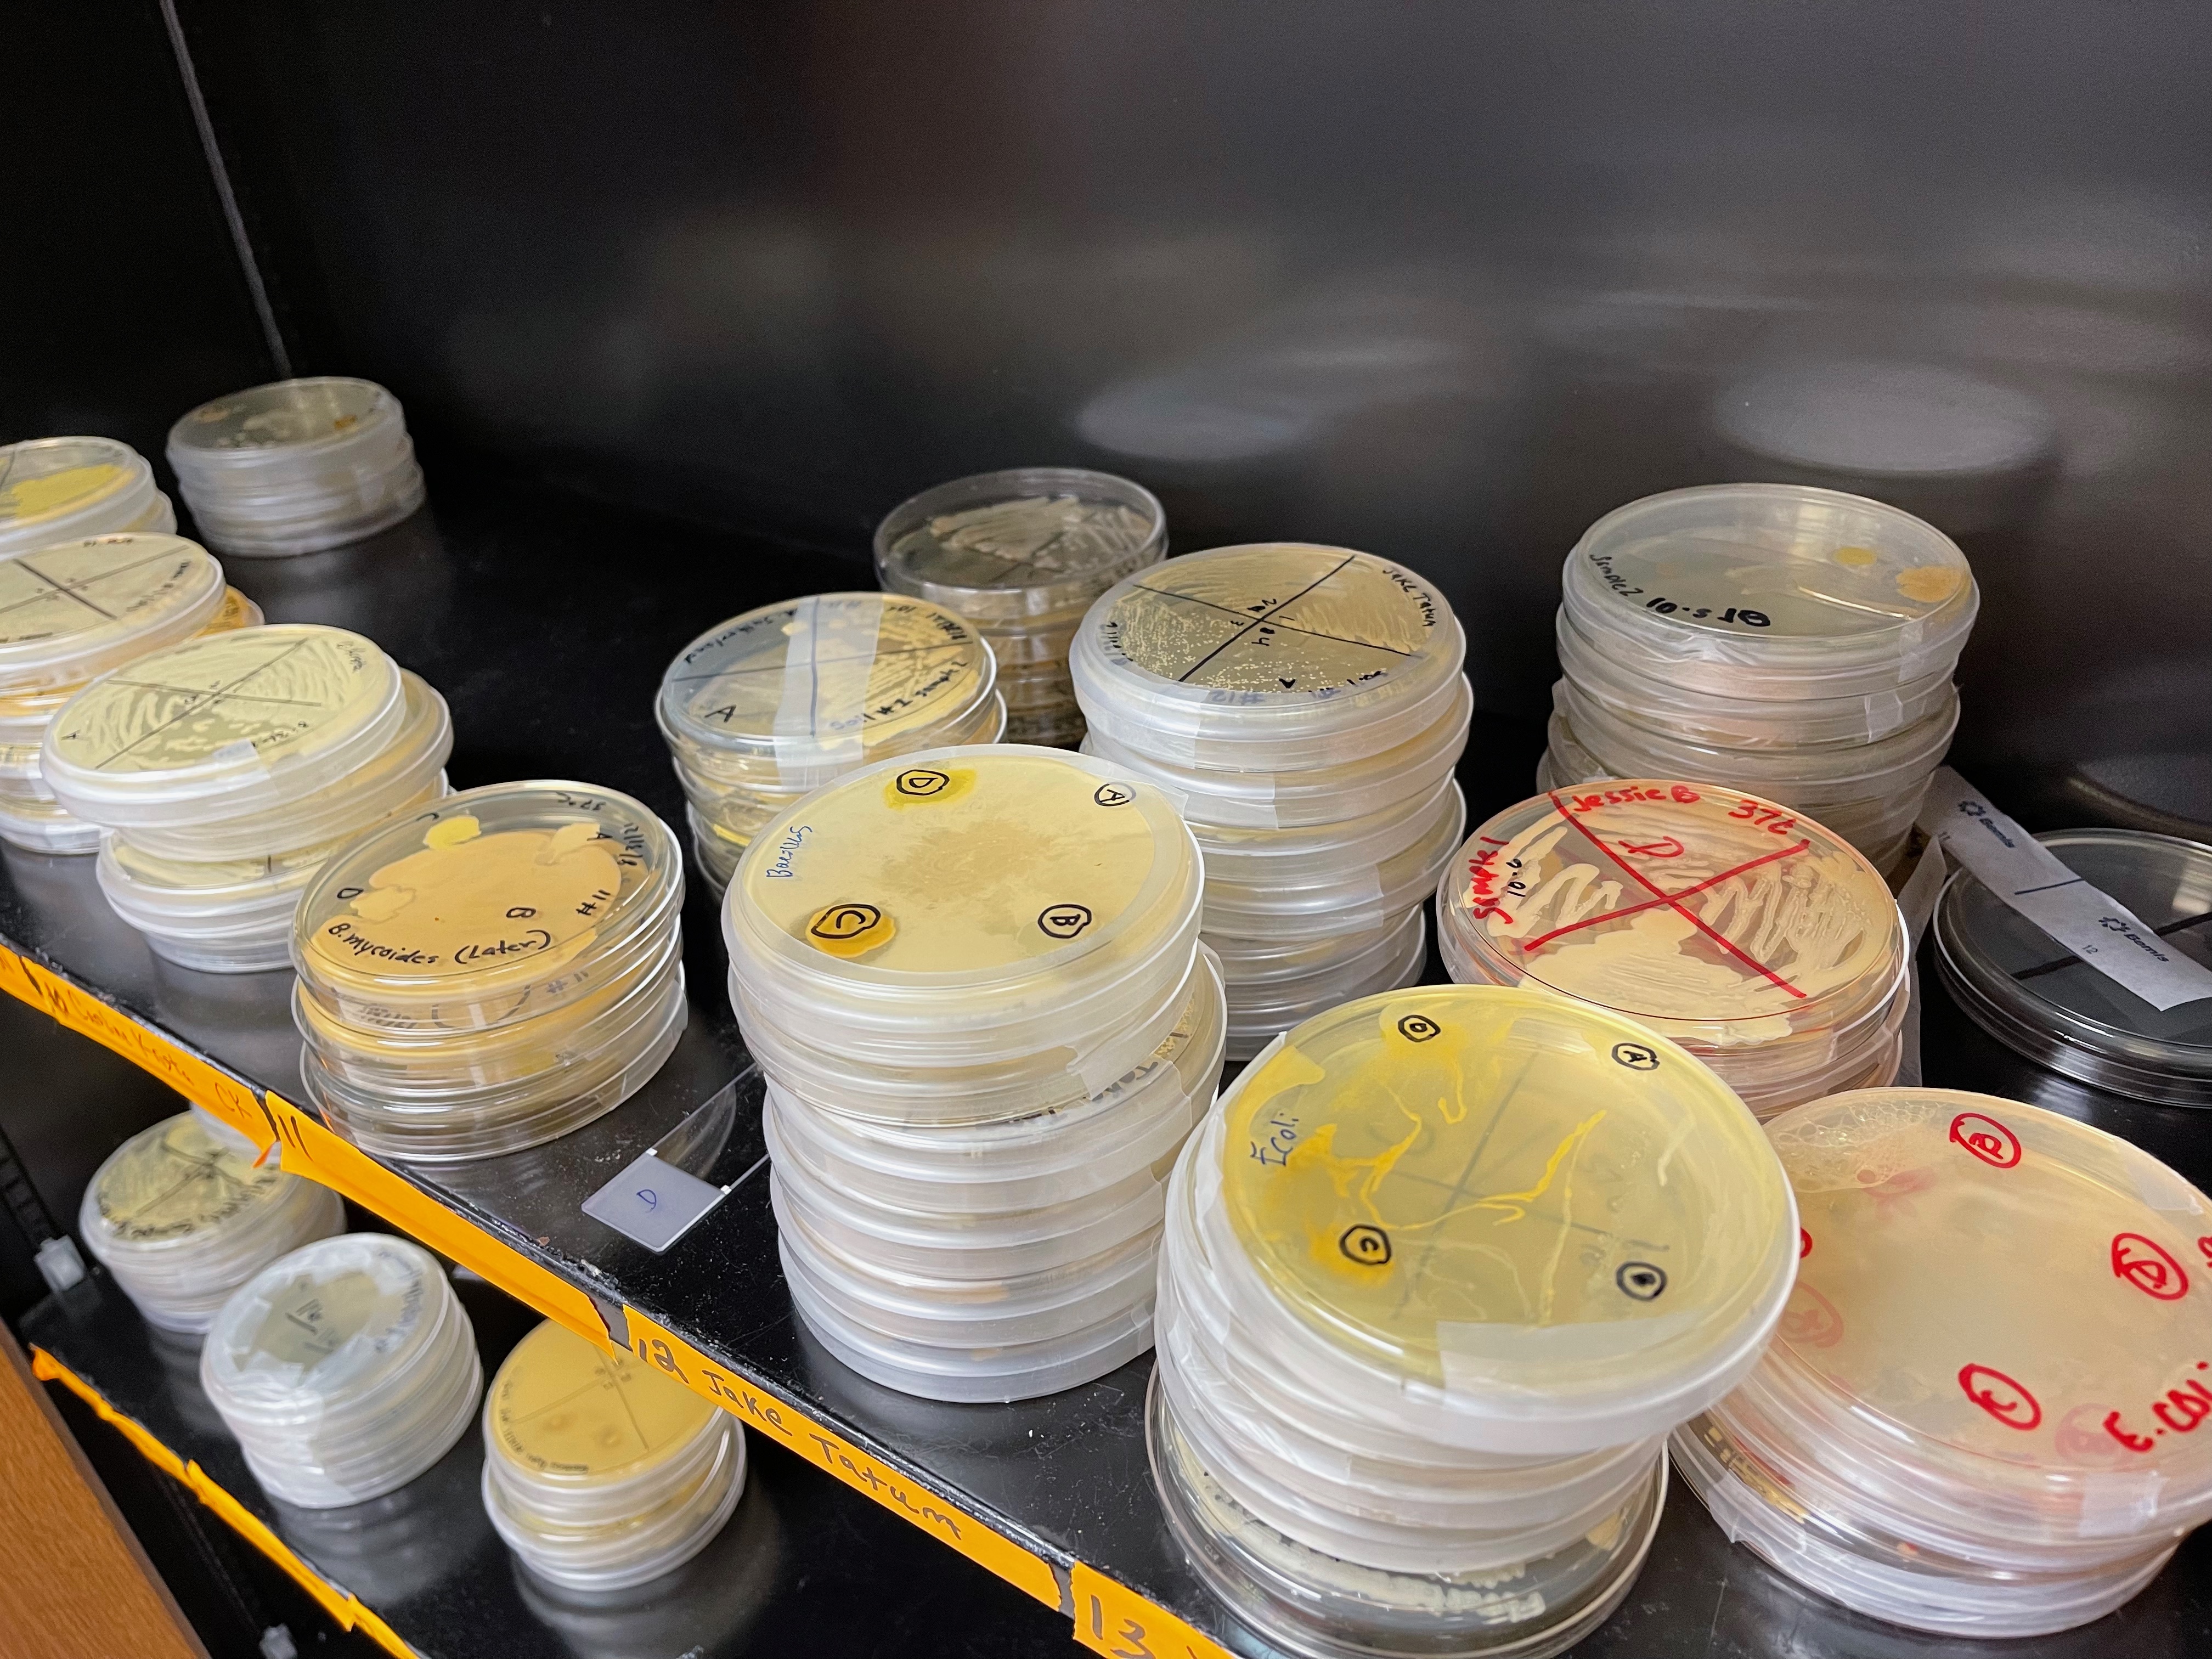

COSAM News Articles 2021 September Research experience opportunities for first year students available in new pilot biology course
Research experience opportunities for first year students available in new pilot biology course
“This pilot project gives us a chance to help undergraduate students engage in research early on,” said Min Zhong, senior lecturer in the Department of Biological Sciences. “Students participating will develop functional lab skills, improve their scientific communication, gain hands-on experience collaborating with other students, and benefit them in the post-graduation setting.”
The University Writing Team awarded an Academy for Writing: Integrating High Impact Practices (HIPs) departmental grant to four faculty in the Department of Biological Sciences: Min Zhong, senior lecturer; Mark Liles, acting associate dean for research and graduate studies; Scott Bowling, instructor and coordinator; Rebecca Riggs, lecturer.
“In a traditional laboratory course, students follow steps in a book and confirm a known outcome,” Zhong explained. “In this pilot project, we are elevating the student experience and empowering them to propose a hypothesis, collect data, conduct analysis and develop an unknown conclusion.”
This new, elevated course will be offered to students in spring 2022. The BIOL 1021 – CURE: The Principles of Biology Lab gives students an opportunity to gain experience in the course that is a Course-based Undergraduate Research Experience (CURE). In this CURE course students will culture microorganisms from soils and other habitats and identify cultures that can produce antibiotics. This antibiotic discovery research project dedicated to “studentsourcing antibiotic discovery” is part of a larger Tiny Earth network of instructors and students at institutions around the world.
“Instead of waiting until their junior or senior year, first-year students will be able to gain the authentic research experience very early on in their undergraduate degree,” Zhong added.
Normally students will seek out research opportunities in labs. This pilot project streamlines the process and gives students the experiences in a required course. Transforming introductory biology labs into CURE will provide a large population of entry-level undergraduates with large-scale research opportunities.
“We have a long-term goal that the Tiny Earth project can be expanded in other upper-level courses. We strive to offer the option for students to continue the Tiny Earth project through developing a vertical alignment of CURE curriculum where we have multiple opportunities for students to conduct their own research so they can become independent thinkers and prepare for a career in a STEM field,” Zhong said.
Latest Headlines
-
04/18/2024
-
04/18/2024
-
04/18/2024
-
04/17/2024
-
04/12/2024